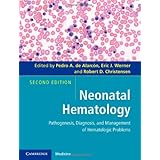
neonatal hematology pathogenesis diagnosis and management of hematologic problems

Ebooks Gratis Neonatal Hematology Pathogenesis Diagnosis And Management Of Hematologic Problems
How can you change your mind to be more open? There many sources that can help you to improve your thoughts. It can be from the other experiences and also story from some people. Book is one of the trusted sources to get. You can find so many books that we share here in this website. And now, we show you one of the best, the neonatal hematology pathogenesis diagnosis and management of hematologic problems.
When going to take the experience or thoughts forms others, book can be a good source. It's true. You can read this neonatal hematology pathogenesis diagnosis and management of hematologic problems as the source that can be downloaded here. The way to download is also easy. You can visit the link page that we offer and then purchase the book to make a deal. Download it and you can put aside in your own device.
Downloading the book in this website lists can give you more advantages. It will show you the best book collections and completed collections. So many books can be found in this website. So, this is not only this neonatal hematology pathogenesis diagnosis and management of hematologic problems. However, this book is referred to read because it is an inspiring book to give you more chance to get experiences and also thoughts. This is simple, read the soft file of the book and you get it.
Your impression of this book will lead you to obtain what you exactly need. As one of the inspiring books, this book will offer the presence of this leaded neonatal hematology pathogenesis diagnosis and management of hematologic problems to collect. Even it is juts soft file; it can be your collective file in gadget and other device. The important is that use this soft file book to read and take the benefits. It is what we mean as book will improve your thoughts and mind. Then, reading book will also improve your life quality better by taking good action in balanced.
Neonatal Hematology Pathogenesis Diagnosis And Management ...
title neonatal hematology pathogenesis diagnosis and management of hematologic problems subject free ebooks neonatal hematology pathogenesis diagnosis and management of hematologic problems and user guide neonatal hematology pathogenesis diagnosis and management of hematologic problems download as reference instruction neonatal hematology pathogenesis diagnosis and management of hematologic
Neonatal Hematology Cambridge University Press
neonatal hematology pathogenesis diagnosis and management of hematologic problems pedro a. de alarcon university of illinois college of medicine peoria il usa eric j. werner children s specialty group children s hospital of the king s daughters and eastern virginia medical school norfolk va usa robert d. christensen
Neonatal Hematology Assets
978 0 521 11931 3 neonatal hematology pathogenesis diagnosis and management of hematologic problems second edition edited by pedro a. de alarcon eric j. werner and robert d. christensen frontmatter more information
Hematologic Problems Neonatal Hematology Pathogenesis ...
neonatal hematology pathogenesis diagnosis and management of hematologic problems alarcon pedro de isbn 13 9780521119313 table of contents foreword preface 1. history of neonatal hematology howard pearson part i. developmental hematology 2. hematopoiesis mervin yoder 3. immunologic system william slayton and angela e. rivers part ii.
Pediatric Hematologyoncology Course Director Ricarchito ...
identify standardized guidelines for diagnosis and treatment of hematologic oncologic conditions such as clinical protocols for the treatment of children with cancer and practice guidelines in the management of patients with sickle cell disease. 2. be aware of new trends and advances in the field of hematology oncology and be
Medical Faculty Ii Medical Level And Mode Faculty Ii Of ...
catheterization of the big vessels. differential diagnosis treatment prognosis in typical neonatal problems infections jaundice congenital malformations. management of healthy baby nursing feeding contact with parents. general pediatrics taking history in children assessment of the childs development in the
Cedars Sinai Medical Center Pediatric Electives
1. gain basic understanding of normal and abnormal hematologic problems in children. 2. basic understanding of pathogenesis and treatment of cancer hematologic disorders in children. 3. inpatient and outpatient management of children with cancer and hematologic problems. 4. observation of cohesive team approach to management of above disorders. 5.
Pediatrics Course Specification
a6 describe causes and pathogenesis the clinical manifestations and differential diagnosis of the most important neonatal pediatric and adolescent problems. a7 identify the appropriate of common diagnostic studies and proper choice among them according to the situation and be able to interpret them.